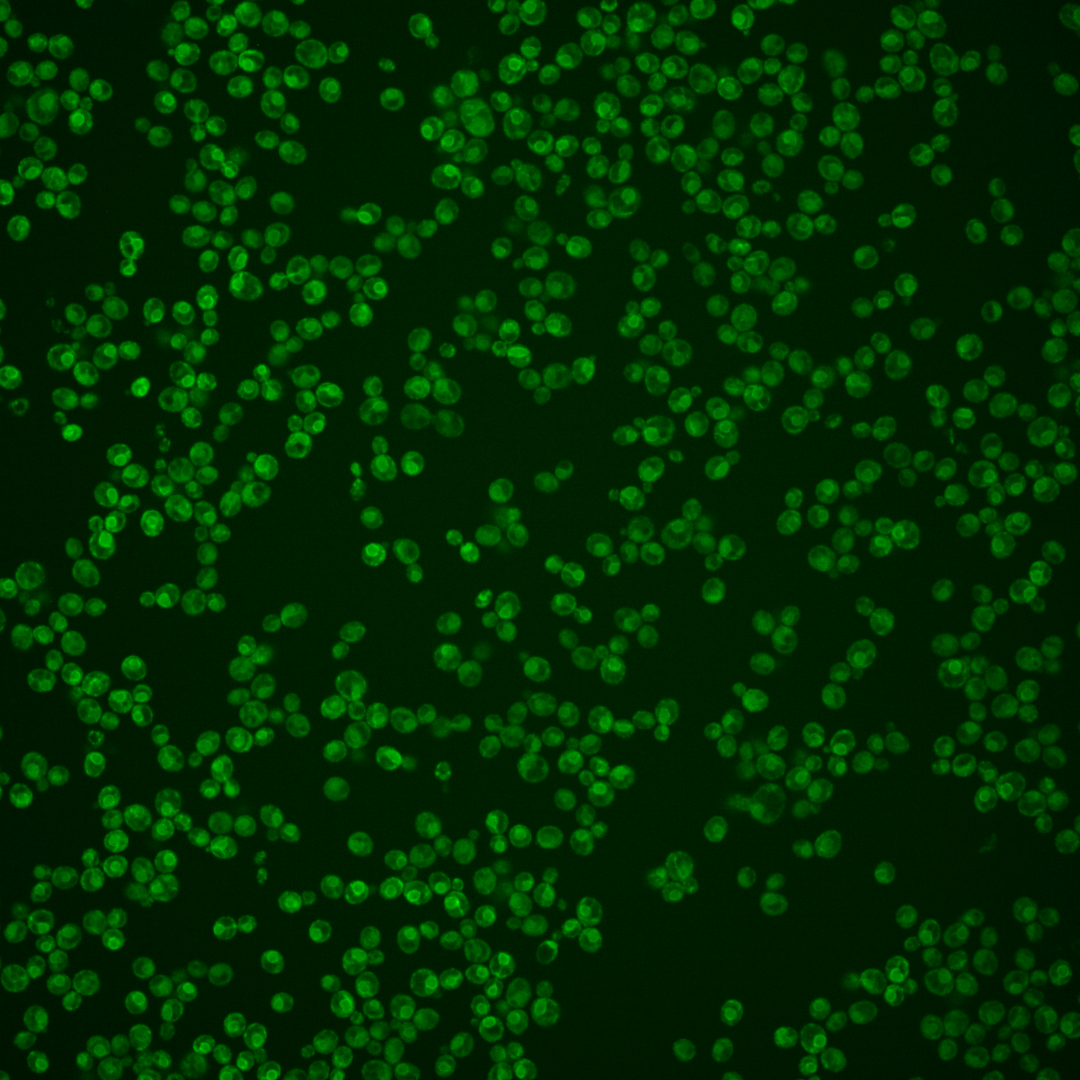
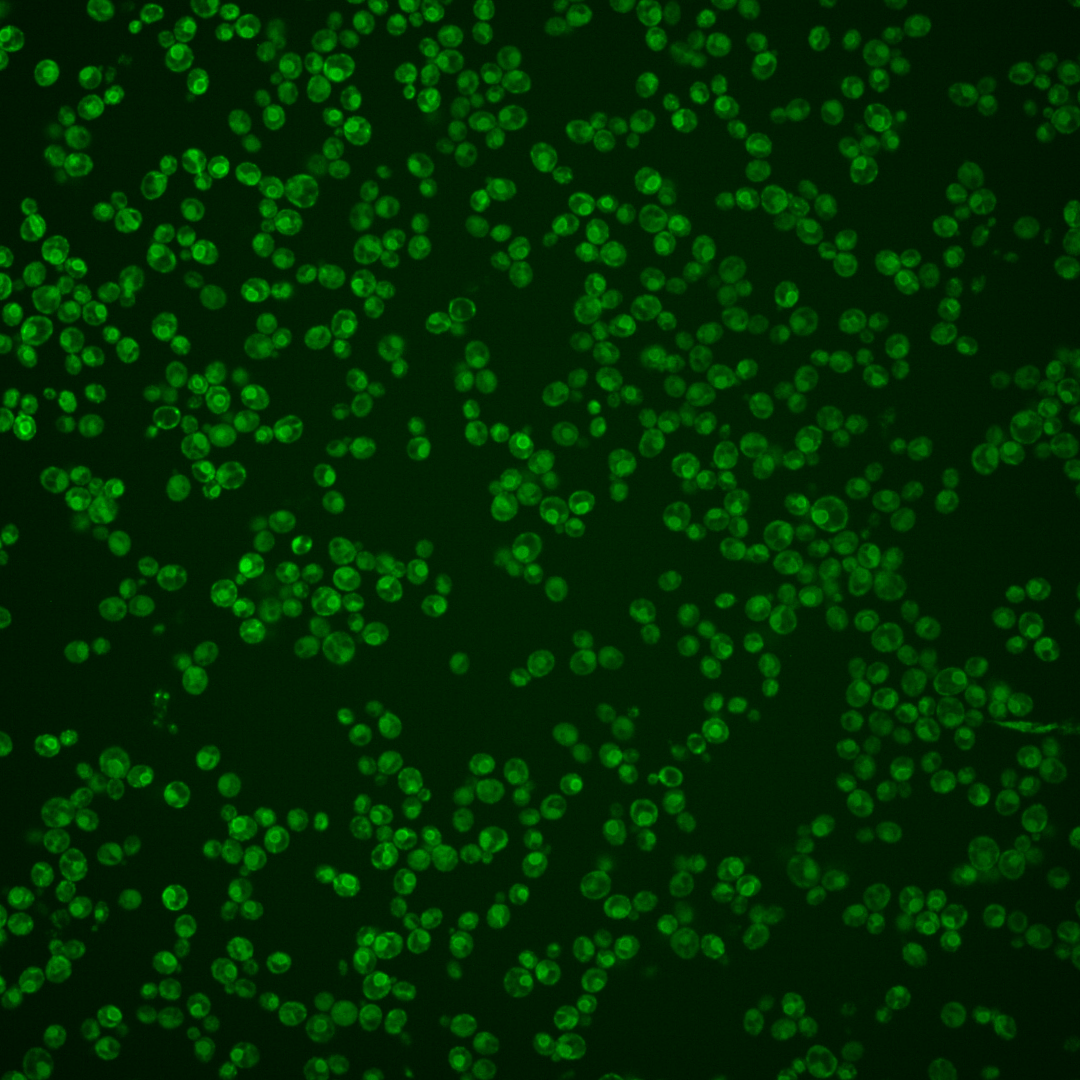
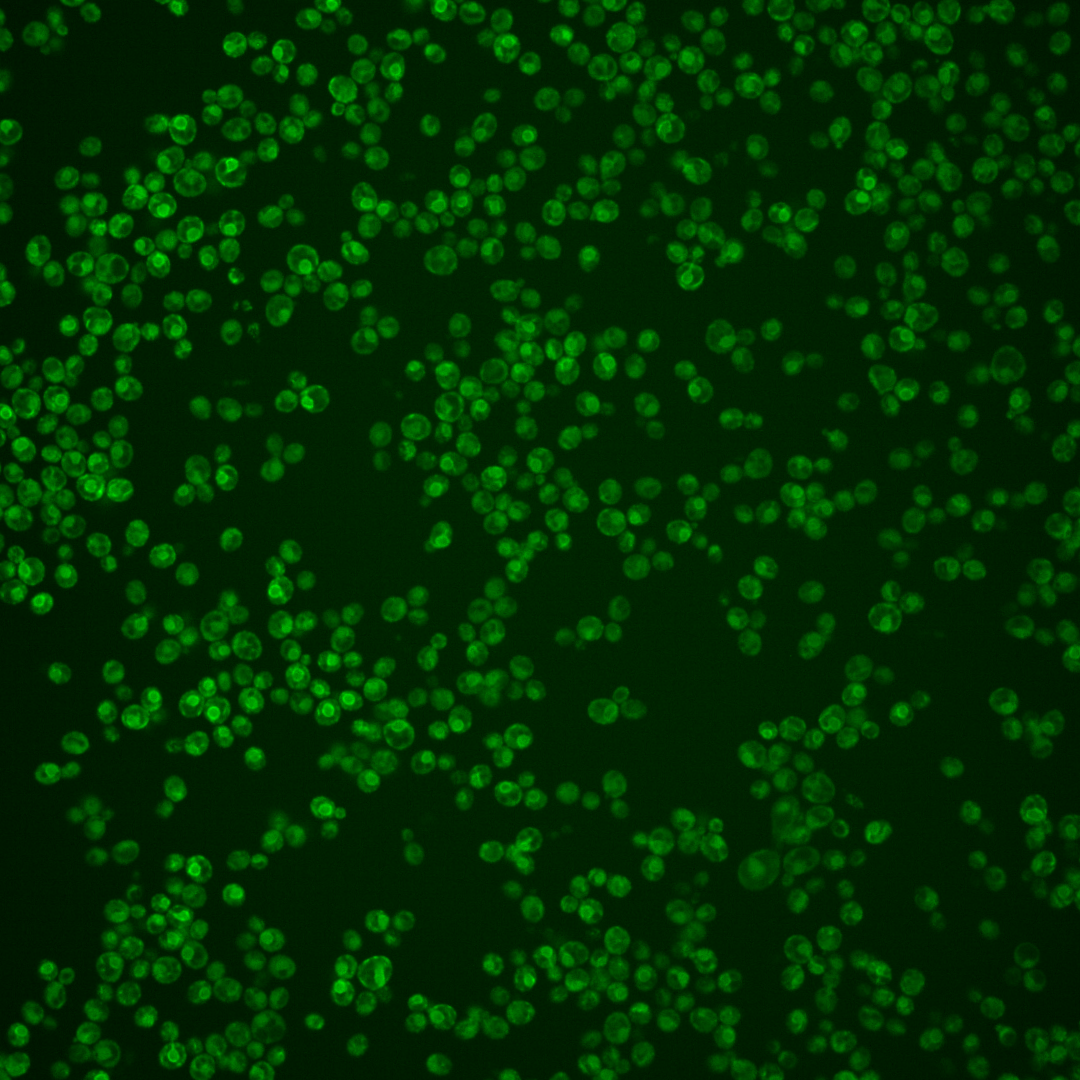

| Standard name | |
|---|---|
| Human Ortholog | |
| Description | Subunit of signal peptidase complex; complex catalyzes cleavage of N-terminal signal sequences of proteins targeted to the secretory pathway; homologous to mammalian SPC22/23; other members of the complex are Spc1p, Spc2p, and Sec11p |
Micrographs




















































































Sub-cellular Localization
Yeast GFP Assignment
Protein Abundance
Localization Change
External localization resources
| ensLOC | DeepLoc | |||||||||||||||||||||||
|---|---|---|---|---|---|---|---|---|---|---|---|---|---|---|---|---|---|---|---|---|---|---|---|---|
| Localization | WT1 | WT2 | WT3 | RAP60 | RAP140 | RAP220 | RAP300 | RAP380 | RAP460 | RAP540 | RAP620 | RAP700 | HU80 | HU120 | HU160 | rpd3Δ_1 | rpd3Δ_2 | rpd3Δ_3 | WT1 | WT2 | WT3 | AF100 | AF140 | AF180 |
| Cortical Patches | 5 | 5 | 7 | 9 | 5 | 9 | 5 | 7 | – | 6 | 4 | 7 | 3 | 2 | 6 | – | – | – | 4 | 7 | 8 | 1 | 3 | 6 |
| Bud | 2 | 1 | 2 | 12 | 8 | 10 | 11 | 15 | – | 14 | 21 | 17 | 0 | 0 | 1 | – | – | – | 2 | 6 | 1 | 3 | 4 | 4 |
| Bud Neck | 0 | 1 | 0 | 0 | 0 | 0 | 0 | 0 | – | 0 | 0 | 0 | 0 | 0 | 0 | – | – | – | 1 | 3 | 1 | 2 | 0 | 0 |
| Bud Site | 0 | 0 | 0 | 0 | 0 | 1 | 0 | 0 | – | 2 | 1 | 0 | 0 | 0 | 0 | – | – | – | – | – | – | – | – | – |
| Cell Periphery | 4 | 5 | 4 | 14 | 10 | 11 | 14 | 15 | – | 17 | 18 | 24 | 2 | 7 | 21 | – | – | – | 1 | 1 | 4 | 1 | 1 | 2 |
| Cytoplasm | 61 | 52 | 59 | 107 | 102 | 87 | 142 | 160 | – | 110 | 100 | 145 | 16 | 28 | 50 | – | – | – | 14 | 17 | 12 | 8 | 6 | 8 |
| Endoplasmic Reticulum | 185 | 96 | 80 | 75 | 80 | 87 | 53 | 56 | – | 70 | 25 | 64 | 29 | 41 | 106 | – | – | – | 247 | 120 | 143 | 42 | 58 | 53 |
| Endosome | 5 | 0 | 0 | 6 | 8 | 1 | 5 | 9 | – | 3 | 3 | 0 | 0 | 0 | 1 | – | – | – | 3 | 0 | 1 | 0 | 1 | 0 |
| Golgi | 2 | 1 | 0 | 1 | 0 | 0 | 0 | 0 | – | 0 | 0 | 0 | 0 | 0 | 2 | – | – | – | 4 | 0 | 0 | 0 | 0 | 3 |
| Mitochondria | 11 | 2 | 35 | 171 | 135 | 124 | 204 | 265 | – | 191 | 192 | 244 | 0 | 0 | 0 | – | – | – | 16 | 13 | 13 | 7 | 10 | 10 |
| Nucleus | 0 | 0 | 0 | 1 | 1 | 2 | 3 | 10 | – | 9 | 7 | 0 | 0 | 0 | 1 | – | – | – | 0 | 0 | 0 | 0 | 0 | 0 |
| Nuclear Periphery | 1 | 2 | 2 | 2 | 1 | 3 | 7 | 2 | – | 4 | 2 | 8 | 0 | 0 | 4 | – | – | – | 0 | 0 | 0 | 0 | 1 | 0 |
| Nucleolus | 1 | 0 | 0 | 0 | 0 | 1 | 0 | 0 | – | 0 | 0 | 0 | 0 | 0 | 0 | – | – | – | 0 | 0 | 0 | 0 | 0 | 0 |
| Peroxisomes | 0 | 0 | 0 | 0 | 0 | 0 | 0 | 0 | – | 0 | 0 | 1 | 0 | 0 | 0 | – | – | – | 0 | 0 | 0 | 0 | 0 | 0 |
| SpindlePole | 0 | 0 | 0 | 0 | 0 | 0 | 0 | 0 | – | 1 | 0 | 0 | 0 | 0 | 1 | – | – | – | 0 | 0 | 1 | 0 | 0 | 1 |
| Vac/Vac Membrane | 34 | 14 | 5 | 21 | 53 | 25 | 66 | 98 | – | 84 | 56 | 39 | 2 | 4 | 1 | – | – | – | 13 | 4 | 5 | 6 | 7 | 4 |
| Unique Cell Count | 272 | 160 | 164 | 329 | 312 | 271 | 397 | 501 | 400 | 327 | 429 | 48 | 75 | 167 | 313 | 178 | 197 | 77 | 99 | 97 | ||||
| Labelled Cell Count | 311 | 179 | 194 | 419 | 403 | 361 | 510 | 637 | 511 | 429 | 549 | 52 | 82 | 194 | 313 | 178 | 197 | 77 | 99 | 97 | ||||
Yeast GFP Assignment
Protein Abundance
| Screen | WT1 | WT2 | WT3 | RAP60 | RAP140 | RAP220 | RAP300 | RAP380 | RAP460 | RAP540 | RAP620 | RAP700 | HU80 | HU120 | HU160 | rpd3Δ_1 | rpd3Δ_2 | rpd3Δ_3 | AF100 | AF140 | AF180 |
|---|---|---|---|---|---|---|---|---|---|---|---|---|---|---|---|---|---|---|---|---|---|
| Mean Cell GFP Intensity (1e-4) | 7.5 | 7.1 | 5.3 | 5.5 | 5.7 | 5.6 | 5.3 | 5.4 | – | 5.1 | 5.1 | 5.3 | 8.3 | 7.9 | 8.1 | – | – | – | 8.4 | 8.7 | 8.8 |
| Std Deviation (1e-4) | 1.7 | 1.7 | 1.3 | 1.5 | 1.8 | 1.5 | 1.6 | 1.5 | – | 1.3 | 1.5 | 1.4 | 2.6 | 2.2 | 1.7 | – | – | – | 2.4 | 2.6 | 2.0 |
| Intensity Change (Log2) | – | – | – | 0.03 | 0.1 | 0.06 | -0.02 | 0.0 | – | -0.07 | -0.07 | -0.02 | 0.64 | 0.57 | 0.59 | – | – | – | 0.65 | 0.71 | 0.72 |
Localization Change
| Localization | RAP60 | RAP140 | RAP220 | RAP300 | RAP380 | RAP460 | RAP540 | RAP620 | RAP700 | HU80 | HU120 | HU160 | rpd3Δ_1 | rpd3Δ_2 | rpd3Δ_3 |
|---|---|---|---|---|---|---|---|---|---|---|---|---|---|---|---|
| Cortical Patches | -0.9 | 0 | -0.5 | 0 | 0 | – | 0 | 0 | 0 | 0 | 0 | -0.3 | – | – | – |
| Bud | 0 | 0 | 0 | 0 | 0 | – | 0 | 2.6 | 1.7 | 0 | 0 | 0 | – | – | – |
| Bud Neck | 0 | 0 | 0 | 0 | 0 | – | 0 | 0 | 0 | 0 | 0 | 0 | – | – | – |
| Bud Site | 0 | 0 | 0 | 0 | 0 | – | 0 | 0 | 0 | 0 | 0 | 0 | – | – | – |
| Cell Periphery | 1.0 | 0 | 0.9 | 0.7 | 0 | – | 1.0 | 1.5 | 1.6 | 0 | 0 | 3.5 | – | – | – |
| Cytoplasm | -0.8 | -0.7 | -0.8 | 0 | -1.0 | – | -2.0 | -1.2 | -0.5 | -0.3 | 0.2 | -1.2 | – | – | – |
| Endoplasmic Reticulum | -5.9 | -5.1 | -3.5 | -9.0 | -10.4 | – | -7.6 | -10.5 | -8.6 | 1.4 | 0.8 | 2.7 | – | – | – |
| Endosome | 0 | 0 | 0 | 0 | 0 | – | 0 | 0 | 0 | 0 | 0 | 0 | – | – | – |
| Golgi | 0 | 0 | 0 | 0 | 0 | – | 0 | 0 | 0 | 0 | 0 | 0 | – | – | – |
| Mitochondria | 6.5 | 4.7 | 5.1 | 6.5 | 7.0 | – | 5.8 | 7.8 | 7.8 | -3.5 | -4.3 | -6.3 | – | – | – |
| Nucleus | 0 | 0 | 0 | 0 | 0 | – | 0 | 0 | 0 | 0 | 0 | 0 | – | – | – |
| Nuclear Periphery | 0 | 0 | 0 | 0 | 0 | – | 0 | 0 | 0 | 0 | 0 | 0 | – | – | – |
| Nucleolus | 0 | 0 | 0 | 0 | 0 | – | 0 | 0 | 0 | 0 | 0 | 0 | – | – | – |
| Peroxisomes | 0 | 0 | 0 | 0 | 0 | – | 0 | 0 | 0 | 0 | 0 | 0 | – | – | – |
| SpindlePole | 0 | 0 | 0 | 0 | 0 | – | 0 | 0 | 0 | 0 | 0 | 0 | – | – | – |
| Vacuole | 1.6 | 4.4 | 2.5 | 4.4 | 5.1 | – | 5.3 | 4.5 | 2.5 | 0 | 0 | 0 | – | – | – |
External localization resources
Images






























Protein Concentration and Protein Localization Data
| R1 | R2 | R3 | ||||||||||||||||
|---|---|---|---|---|---|---|---|---|---|---|---|---|---|---|---|---|---|---|
| G1 Pre-START | G1 Post-START | S/G2 | Metaphase | Anaphase | Telophase | G1 Pre-START | G1 Post-START | S/G2 | Metaphase | Anaphase | Telophase | G1 Pre-START | G1 Post-START | S/G2 | Metaphase | Anaphase | Telophase | |
| Concentration | 3.7882 | 3.8046 | 3.2772 | 2.8932 | 3.5686 | 3.6555 | 4.6373 | 5.4238 | 5.5489 | 4.4566 | 4.4104 | 4.9763 | 2.802 | 3.6572 | 2.9702 | 2.3958 | 3.0709 | 3.1861 |
| Actin | 0.0261 | 0.0011 | 0.002 | 0.0094 | 0.0003 | 0.002 | 0.0253 | 0.0034 | 0.0031 | 0.0065 | 0.0332 | 0.0007 | 0.0093 | 0.0007 | 0.0006 | 0.0022 | 0.0005 | 0.0015 |
| Bud | 0.0001 | 0.0001 | 0 | 0.0001 | 0 | 0.0001 | 0.0001 | 0.0014 | 0.0001 | 0.0001 | 0.0061 | 0.0001 | 0.0001 | 0.0001 | 0.0001 | 0.0001 | 0 | 0 |
| Bud Neck | 0.0006 | 0.0004 | 0.0012 | 0.0283 | 0.0011 | 0.0008 | 0.0004 | 0.0005 | 0.0002 | 0.0154 | 0.0008 | 0.0008 | 0.0003 | 0.0001 | 0.0003 | 0.0001 | 0.0001 | 0.0021 |
| Bud Periphery | 0.0002 | 0.0002 | 0.0001 | 0.0001 | 0.0001 | 0.0004 | 0.0002 | 0.0082 | 0.0001 | 0.0002 | 0.0035 | 0.0004 | 0.0002 | 0.0004 | 0.0002 | 0.0004 | 0 | 0.0001 |
| Bud Site | 0.0005 | 0.0017 | 0.0142 | 0.0003 | 0 | 0.0001 | 0.0003 | 0.0052 | 0.001 | 0.0003 | 0.0004 | 0.0004 | 0.0002 | 0.0005 | 0.0007 | 0.0001 | 0 | 0.0001 |
| Cell Periphery | 0.0009 | 0.0029 | 0.0018 | 0.0009 | 0.0008 | 0.0066 | 0.0026 | 0.0081 | 0.0026 | 0.0015 | 0.0018 | 0.0013 | 0.001 | 0.0017 | 0.0012 | 0.0021 | 0.0002 | 0.0008 |
| Cytoplasm | 0.092 | 0.17 | 0.1133 | 0.0251 | 0.0733 | 0.1042 | 0.0581 | 0.1249 | 0.1273 | 0.1711 | 0.0809 | 0.151 | 0.0627 | 0.102 | 0.0799 | 0.0713 | 0.1053 | 0.0982 |
| Cytoplasmic Foci | 0.0095 | 0.0042 | 0.0025 | 0.0184 | 0.0014 | 0.0122 | 0.0064 | 0.0073 | 0.0083 | 0.0146 | 0.009 | 0.0044 | 0.0062 | 0.0052 | 0.0046 | 0.0013 | 0.0023 | 0.0042 |
| Eisosomes | 0.0002 | 0.0002 | 0.0002 | 0.0001 | 0 | 0.0001 | 0.0014 | 0.0004 | 0.0002 | 0.0003 | 0.0043 | 0.0001 | 0.0005 | 0.0001 | 0.0001 | 0.0001 | 0 | 0.0003 |
| Endoplasmic Reticulum | 0.7552 | 0.7065 | 0.7788 | 0.8685 | 0.905 | 0.8016 | 0.8001 | 0.725 | 0.7731 | 0.6135 | 0.7369 | 0.7623 | 0.816 | 0.8141 | 0.8535 | 0.8435 | 0.8648 | 0.8072 |
| Endosome | 0.0208 | 0.0134 | 0.0078 | 0.0147 | 0.0068 | 0.0149 | 0.0177 | 0.0099 | 0.0057 | 0.0157 | 0.0323 | 0.0177 | 0.021 | 0.0165 | 0.0124 | 0.0033 | 0.0083 | 0.0106 |
| Golgi | 0.0049 | 0.0024 | 0.0009 | 0.0041 | 0.0008 | 0.0034 | 0.0094 | 0.0025 | 0.002 | 0.0037 | 0.0166 | 0.0029 | 0.0046 | 0.0013 | 0.0008 | 0.0008 | 0.0014 | 0.0013 |
| Lipid Particles | 0.0118 | 0.0104 | 0.0052 | 0.0045 | 0.0013 | 0.0053 | 0.0153 | 0.0129 | 0.0102 | 0.025 | 0.0089 | 0.0084 | 0.009 | 0.0056 | 0.0072 | 0.0023 | 0.0008 | 0.0041 |
| Mitochondria | 0.0012 | 0.0004 | 0.0003 | 0.0005 | 0.0002 | 0.0011 | 0.0017 | 0.0012 | 0.0008 | 0.0025 | 0.0016 | 0.0038 | 0.008 | 0.0009 | 0.0007 | 0.0004 | 0.0003 | 0.0056 |
| None | 0.0264 | 0.0625 | 0.0585 | 0.0007 | 0.0015 | 0.0339 | 0.0335 | 0.0709 | 0.0446 | 0.0586 | 0.0258 | 0.0321 | 0.0223 | 0.0308 | 0.0227 | 0.0607 | 0.0017 | 0.0465 |
| Nuclear Periphery | 0.0272 | 0.0139 | 0.0091 | 0.0174 | 0.0039 | 0.0086 | 0.0119 | 0.0085 | 0.0077 | 0.0173 | 0.0181 | 0.0063 | 0.021 | 0.009 | 0.0093 | 0.0067 | 0.0103 | 0.0092 |
| Nucleolus | 0.0003 | 0.0002 | 0 | 0 | 0 | 0.0001 | 0.0002 | 0.0002 | 0.0001 | 0.0002 | 0.0003 | 0.0002 | 0.0013 | 0.0001 | 0.0001 | 0 | 0 | 0.0001 |
| Nucleus | 0.0075 | 0.002 | 0.0007 | 0.001 | 0.0006 | 0.0009 | 0.0022 | 0.0024 | 0.001 | 0.0025 | 0.0046 | 0.0012 | 0.0065 | 0.0012 | 0.001 | 0.001 | 0.0015 | 0.0022 |
| Peroxisomes | 0.0031 | 0.0001 | 0.0001 | 0.0009 | 0 | 0.0003 | 0.0069 | 0.0003 | 0.0074 | 0.0421 | 0.0044 | 0.0002 | 0.001 | 0 | 0.0001 | 0 | 0 | 0.0001 |
| Punctate Nuclear | 0.007 | 0.001 | 0.0003 | 0.0011 | 0.0001 | 0.0011 | 0.0023 | 0.001 | 0.0006 | 0.0013 | 0.0037 | 0.0004 | 0.0033 | 0.0003 | 0.0004 | 0.0003 | 0.0002 | 0.0017 |
| Vacuole | 0.0034 | 0.006 | 0.0026 | 0.0029 | 0.0026 | 0.0021 | 0.003 | 0.0051 | 0.0035 | 0.0066 | 0.0056 | 0.0047 | 0.0041 | 0.0085 | 0.0038 | 0.0028 | 0.0019 | 0.0034 |
| Vacuole Periphery | 0.0009 | 0.0005 | 0.0004 | 0.0008 | 0.0003 | 0.0004 | 0.0008 | 0.0009 | 0.0004 | 0.001 | 0.0013 | 0.0007 | 0.0015 | 0.0008 | 0.0005 | 0.0003 | 0.0002 | 0.0005 |
Sequencing Data
| R1 | R2 | |||||||||
|---|---|---|---|---|---|---|---|---|---|---|
| G1 Post-START | S/G2 | Metaphase | Anaphase | Telophase | G1 Post-START | S/G2 | Metaphase | Anaphase | Telophase | |
| Gene Expression | 76.5425 | 33.7678 | 31.6512 | 56.7102 | 48.9759 | 57.6234 | 53.9094 | 54.5778 | 44.9496 | 64.3702 |
| Translational Efficiency | 1.3503 | 1.8221 | 1.9996 | 1.2675 | 1.3431 | 1.4768 | 1.269 | 1.053 | 1.4057 | 1.1644 |
Hit Data
| Dataset | Hit |
|---|---|
| Protein Concentration | ✘ |
| Protein Localization | ✘ |
| Gene Expression | ✘ |
| Translational Efficiency | ✘ |
Endocytosis
| Temp | Actin Patch (Sac6-tdTomato) | Cortical Patch (Sla1-GFP) | Late Endosome (Snf7-GFP) | Vacuole (Vph1-GFP) |
|---|---|---|---|---|
| 37℃ | ||||
| RT |
Cell Cycle Omics
CYCLoPs (Spc3-GFP)
| Gene / Allele | Actin Patch (Sac6-tdTomato) | Cortical Patch (Sla1-GFP) | Late Endosome (Snf7-GFP) | Vacuole (Sac6-tdTomato) |
|---|
| Gene | Images |
|---|
| Gene | Images |
|---|
Images are not yet available
Images are not yet available